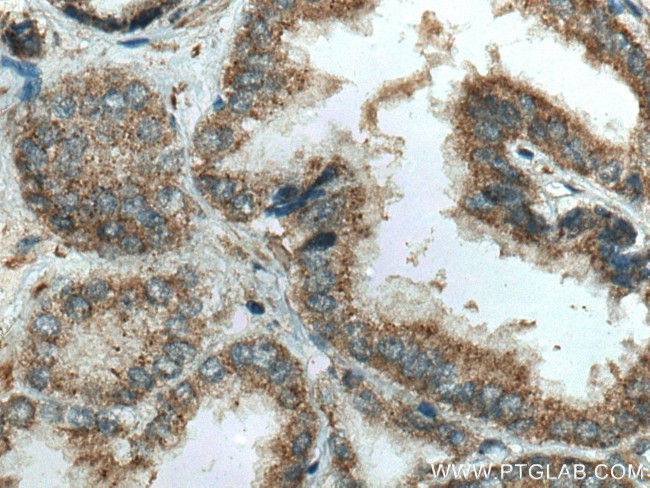
IkB Alpha Antibody in Immunohistochemistry (Paraffin) (IHC (P))

Search
Proteintech
IkB Alpha Recombinant Rabbit Monoclonal Antibody (5C24)
{{$productOrderCtrl.translations['antibody.pdp.commerceCard.promotion.promotions']}}
{{$productOrderCtrl.translations['antibody.pdp.commerceCard.promotion.viewpromo']}}
{{$productOrderCtrl.translations['antibody.pdp.commerceCard.promotion.promocode']}}: {{promo.promoCode}} {{promo.promoTitle}} {{promo.promoDescription}}. {{$productOrderCtrl.translations['antibody.pdp.commerceCard.promotion.learnmore']}}
产品信息
80019-1-RR100UL
种属反应
宿主/亚型
Expression System
分类
类型
克隆号
偶联物
形式
浓度
纯化类型
保存液
内含物
保存条件
运输条件
靶标信息
IkB-alpha is a 40 kDa protein that functions to inhibit NF- kappaB activity. The inhibition occurs via protein-protein interaction between I kappaB proteins and NF- kappaB dimers in the cytosol. The interaction of I kappa B-alpha with NF- kappaB masks the nuclear localization sequence of NF- kappaB, preventing NF- kappaB translocation to the nucleus. A variety of stimuli can activate gene expression by liberating NF- kappaB through the degradation of I kappaB alpha. These stimuli include the proinflammatory cytokines TNF- alpha and IL-1 beta, chemokines, PMA, growth factors, LPS, UV irradiation, viral infection, as well as various chemical and physical stresses. In humans, the gene is located on the q arm of chromosome 14. Activation of NFkB requires that IkB be phosphorylated on specific serine residues, which results in targeted degradation of IkB. IkB kinase alpha (IKK alpha), previously designated CHUK, interacts with IkB-alpha and specifically phosphorylates IkB-alpha on the sites that trigger its degradation Serines 32 and 36. IKK alpha appears to be critical for NFkB activation in response to proinflammatory cytokines. Phosphorylation of IkB by IKK alpha is stimulated by the NFkB inducing kinase (NIK), which itself is a central regulator for NFkB activation in response to TNF and IL-1. The functional IKK complex contains three subunits, IKK alpha, IKK beta and IKK gamma, and each appear to make essential contributions to IkB phosphorylation.
仅用于科研。不用于诊断过程。未经明确授权不得转售。
篇参考文献 (0)
生物信息学
蛋白别名: I(Kappa)B(alpha); I-kappa-B-alpha; I-kappaBalpha; IkappaBalpha; IkB-alpha; IKBalpha; Inhibitor of nuclear factor of kappa light chain gene enhancer in B-cells alpha; Inhibitor of nuclear factor of kappa light chain gene enhancer in B-cells, alpha; Major histocompatibility complex enhancer-binding protein MAD3; NF-kappa-B inhibitor alpha; nuclear factor of kappa light chain gene enhancer in B-cells; nuclear factor of kappa light chain gene enhancer in B-cells inhibitor, alpha; nuclear factor of kappa light polyp gene enhancer in B-cell 1; nuclear factor of kappa light polypeptide gene enhancer in B-cells inhibitor, alpha; RL/IF-1
基因别名: AI462015; IKBA; MAD-3; MAD3; NFKBI; NFKBIA; RL/IF-1
UniProt ID: (Human) P25963, (Rat) Q63746, (Mouse) Q9Z1E3
Entrez Gene ID: (Human) 4792, (Rat) 25493, (Mouse) 18035